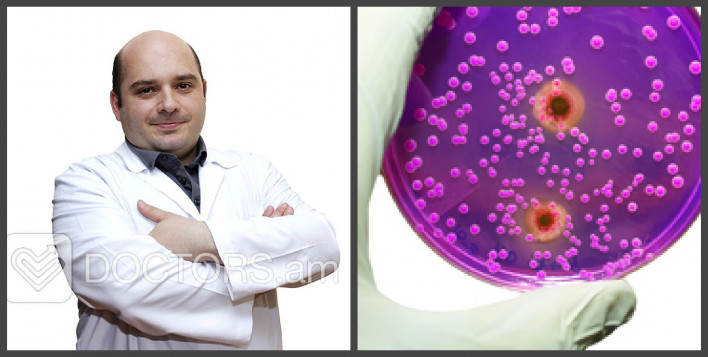

«Տղամարդիկ սովորաբար բացառում են սեռավարակակիր լինելը.սեռավարակների մասին մտածում են, երբ գանգատ ունեն». Հովհաննես Հովհաննիսյան (video)


 Սևանի գերեզմանատանը երիտասարդ տղայի մարմին է հայտնաբերվել
Սևանի գերեզմանատանը երիտասարդ տղայի մարմին է հայտնաբերվել
 Դատավորների ընդհանուր ժողովն ընտրել է Էթիկայի և կարգապահական հարցերի հանձնաժողովի նոր անդամների
Դատավորների ընդհանուր ժողովն ընտրել է Էթիկայի և կարգապահական հարցերի հանձնաժողովի նոր անդամների
 Այդ քննարկումներն ինձ ստիպեցին ավելի խորությամբ վերլուծել իրավիճակը. Մելիքյան
Այդ քննարկումներն ինձ ստիպեցին ավելի խորությամբ վերլուծել իրավիճակը. Մելիքյան
 Չկա մի նահատակ, որ նահատակվել է Արցախում, բայց դա չի եղել հանուն Հայաստանի․ Քրիստինե Վարդանյան
Չկա մի նահատակ, որ նահատակվել է Արցախում, բայց դա չի եղել հանուն Հայաստանի․ Քրիստինե Վարդանյան
 Փոստանջյանը դիմել է ՌԴ, ԵՄ և ԱՄՆ դեսպաններին՝ ահազանգելով քաղաքական հետապնդումների մասին
Փոստանջյանը դիմել է ՌԴ, ԵՄ և ԱՄՆ դեսպաններին՝ ահազանգելով քաղաքական հետապնդումների մասին
 Մոջթաբա Խամենեին չի մասնակցի հոր հուղարկավորությանը
Մոջթաբա Խամենեին չի մասնակցի հոր հուղարկավորությանը
 Խոշոր հրդեհ՝ Արմավիրի մարզում․ բակում կայանված «ՎԱԶ 2107»-ը վերածվել է մոխրակույտի
Խոշոր հրդեհ՝ Արմավիրի մարզում․ բակում կայանված «ՎԱԶ 2107»-ը վերածվել է մոխրակույտի
 Գիշերները տաքանում են ավելի արագ, քան ցերեկները՝ մեծացնելով մարդկանց առողջության համար վտանգը
Գիշերները տաքանում են ավելի արագ, քան ցերեկները՝ մեծացնելով մարդկանց առողջության համար վտանգը
 Իրանի ԱԳ նախարարն ու Իրաքի Քուրդիստանի նախագահը քննարկել են տարածաշրջանային վերջին զարգացումները
Իրանի ԱԳ նախարարն ու Իրաքի Քուրդիստանի նախագահը քննարկել են տարածաշրջանային վերջին զարգացումները
 Իսրայելի ավիահարվածների հետևանքով Լիբանանում զոհերի թիվը հասել է 4301-ի
Իսրայելի ավիահարվածների հետևանքով Լիբանանում զոհերի թիվը հասել է 4301-ի
 Երբ ՍԴ-ն կհրապարակի ընտրությունների արդյունքների վերաբերյալ որոշումը
Երբ ՍԴ-ն կհրապարակի ընտրությունների արդյունքների վերաբերյալ որոշումը
 Անդրանիկ Թևանյանը Ալեն Սիմոնյանի դեմ դատական հայց է ներկայացրել
Անդրանիկ Թևանյանը Ալեն Սիմոնյանի դեմ դատական հայց է ներկայացրել
 Սևանի գերեզմանատանը մեքենայում երիտասարդ տղայի մարմին է հայտնաբերվել
Սևանի գերեզմանատանը մեքենայում երիտասարդ տղայի մարմին է հայտնաբերվել
 Պայթյուն՝ Վանաձորի գազալցակայաններից մեկի պահեստային մասում. նախնական տվյալներով՝ կա մեկ տուժած
Պայթյուն՝ Վանաձորի գազալցակայաններից մեկի պահեստային մասում. նախնական տվյալներով՝ կա մեկ տուժած
 Բագրատ սրբազանը դատարանում հաղթել է Անի Խաչատրյանին ու նրա կուսակցին․ «News.5tv.am»
Բագրատ սրբազանը դատարանում հաղթել է Անի Խաչատրյանին ու նրա կուսակցին․ «News.5tv.am»
 Ավտովթար՝ Կոտայքի մարզում. «Lada»-ն բախվել է երկաթե արգելապատնեշին. կան վիրավորներ
Ավտովթար՝ Կոտայքի մարզում. «Lada»-ն բախվել է երկաթե արգելապատնեշին. կան վիրավորներ
 Երևանի խաղահրապարակում վնասված սղարանից երեխա է ընկել
Երևանի խաղահրապարակում վնասված սղարանից երեխա է ընկել
 Իսրայելը հայտարարել է Լիբանանում «Հեզբոլլահ»-ի 10 օբյեկտի հարվածելու մասին
Իսրայելը հայտարարել է Լիբանանում «Հեզբոլլահ»-ի 10 օբյեկտի հարվածելու մասին
 Շինհրապարակներում փոշենստեցման և փոշեճնշիչ միջոցառումները պարտադիր են
Շինհրապարակներում փոշենստեցման և փոշեճնշիչ միջոցառումները պարտադիր են
 #ՀԻՄԱ․ Քաղկալանավայր՝ բաց երկնքի տակ․ ինչ է բուծել Ուրսուլան Հայաստանում․․․ (video)
#ՀԻՄԱ․ Քաղկալանավայր՝ բաց երկնքի տակ․ ինչ է բուծել Ուրսուլան Հայաստանում․․․ (video)
 Նիկո՛լ, լավ էս ինչ խայտառակություն է․ Երվանդ Բոզոյանից ի՞նչ ես ուզում․ Անժելա Թովմասյան (video)
Նիկո՛լ, լավ էս ինչ խայտառակություն է․ Երվանդ Բոզոյանից ի՞նչ ես ուզում․ Անժելա Թովմասյան (video)
 «Ինչու՞ Նիկոլն Ալենին փոխեց Ռուբինյանով»․ Հայկ Նահապետյան (video)
«Ինչու՞ Նիկոլն Ալենին փոխեց Ռուբինյանով»․ Հայկ Նահապետյան (video)
 Պատերազմը հենց Փաշինյանի օրոք է եղել՝ ծախված, միտումնավոր պատերազմ․ Հարցում (video)
Պատերազմը հենց Փաշինյանի օրոք է եղել՝ ծախված, միտումնավոր պատերազմ․ Հարցում (video)
 Աղետալի․ անցած տարի արտահանվել է 50 հազար տոննա ծիրան, այս տարի՝ 8000 տոննա ծիրան չկա Հայաստանում (video)
Աղետալի․ անցած տարի արտահանվել է 50 հազար տոննա ծիրան, այս տարի՝ 8000 տոննա ծիրան չկա Հայաստանում (video)
 Ասեմ՝ ինչ է Բաքվում Ուրսուլա ֆոն դեր Լայենը պայմանավորվել Ալիևի հետ․ Հայկ Նահապետյան (video)
Ասեմ՝ ինչ է Բաքվում Ուրսուլա ֆոն դեր Լայենը պայմանավորվել Ալիևի հետ․ Հայկ Նահապետյան (video)
 Պուտինը կոպիտ ձևով մերժել է Փաշինյանին (video)
1
Պուտինը կոպիտ ձևով մերժել է Փաշինյանին (video)
1
 Նիկոլը գնում է Ռուսաստան․ էդ ենոքավանցուն ասել են՝ շուստրիությունդ Պուտինի մոտ չի անցնելու․ Մալխասյան (video)
2
Նիկոլը գնում է Ռուսաստան․ էդ ենոքավանցուն ասել են՝ շուստրիությունդ Պուտինի մոտ չի անցնելու․ Մալխասյան (video)
2
 «Ինչու՞ Նիկոլն Ալենին փոխեց Ռուբինյանով»․ Հայկ Նահապետյան (video)
3
«Ինչու՞ Նիկոլն Ալենին փոխեց Ռուբինյանով»․ Հայկ Նահապետյան (video)
3
 Աղետալի․ անցած տարի արտահանվել է 50 հազար տոննա ծիրան, այս տարի՝ 8000 տոննա ծիրան չկա Հայաստանում (video)
4
Աղետալի․ անցած տարի արտահանվել է 50 հազար տոննա ծիրան, այս տարի՝ 8000 տոննա ծիրան չկա Հայաստանում (video)
4
«Հենց այդ գիշեր երևաց Նիկոլ Փաշինյանի իրական վախը»․ Արեգա Հովսեփյան («Ուժեղ Հայաստան») (video)
5
«Հենց այդ գիշեր երևաց Նիկոլ Փաշինյանի իրական վախը»․ Արեգա Հովսեփյան («Ուժեղ Հայաստան») (video)
5

